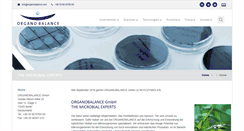

organoasia.com
organoasia.com
Organo Asia Sdn Bhd
Content on this page requires a newer version of Adobe Flash Player.
 organoasxolies.blogspot.com
organoasxolies.blogspot.com
Οργανοασχολίες
Εμπειρίες από την κατασκευή οργάνων. Πέμπτη, 22 Μαρτίου 2012. Βέβαια για ένα αρχάριο τίποτε δεν είναι εύκολο. Αν και μου έλεγε πως και με πια σειρά να το δουλέψω, θέλει εξοικείωση με ορισμένες διαδικασίες για να τις πετύχεις. Άσε που, ότι ένας έμπειρος θεωρεί απλό, για σένα μπορεί να είναι βουνό. Έπρεπε λοιπόν εξ αρχής να σκέφτομαι κάθε βήμα, πριν το κάνω, για το πως θα το κάνω. Να φέρω ένα παράδειγμα. Πλάτη με 7 ντούγιες ίσου πλάτους. Πλάτη με 9 ντούγιες διαφορετικού πλάτους. Η προσωπική μου ιστοσελίδα.
 organobalance-medical.biz
organobalance-medical.biz
ORGANOBALANCE Medical AG
 organobalance-medical.com
organobalance-medical.com
ORGANOBALANCE Medical AG
 organobalance.de
organobalance.de
ORGANOBALANCE GMBH
Pylopass gegen Helicobacter pylori. Geb12, Etage 3. Tel: 49 30 9210765-50. Fax: 49 30 46307-210. Seit September 2016 gehört ORGANOBALANCE GmbH zu NOVOZYMES A/S. Weiterhin leisten wir unseren Beitrag zur Lösung zukünftiger Herausforderungen der modernen Gesellschaft durch die Entwicklung von effizienten Produktionsorganismen für Stoffsynthesen. Unsere wissenschaftliche und technische Expertise und unseren Einfallsreichtum setzen wir ein, um nachhaltige Lösungen zu gestalten. Website Age of Biology. Prof D...
 organobernasconivergiate.it
organobernasconivergiate.it
organo Bernasconi Vergiate | sito dell'organo Bernasconi, chiesa di S. Martino Vergiate
Direzione Artistica e contatti. Videogallery di registrazioni effettuate sull'organo e di artisti scelti More. Immagini del restauro e degli artisti ospiti More. Le biografie di tutti gli artisti ospiti delle stagioni musicali More. Calendario e programmi dei concerti d'organo e delle rassegne musicali More. Senza musica, la vita sarebbe un errore. Organo Bernasconi Vergiate 2009 - webdesign: Federica Peruzzo. Direzione Artistica e contatti.
 organobiotech.com
organobiotech.com
Sodium Citrate,Sodium Hypochlorite,Sodium Citrate Solution,Sodium Hypochlorite Solution,India.
Your Enquiry has been sent successfully. Ultra Pure R.G.T.D Water. Blood Pressure Monitor Back. Reagents Used In Laboratory. Biochemistry Products And Reagent Kit. Organo Biotech Laboratories Private Limited. We Organo Biotech Laboratories Private Limited. Started in the year 2000. Under the headship of our mentor Mr. Rajinder Chopra. Our organization is moving ahead in this cutting-edge competition. He, with his knowledge and expertise, has enabled us to cater the demands of customers. I want to buy.
 organobismuth.com
organobismuth.com
Organic Metal Catalysts (Tin,Bismuth,Zinc,Zr)|Amine Catalysts|FRS|Polyurethane|Silicone Sealant
Changzhou Chemistar,established in 2009,has professional service and superior products in Polyurethane,Silicone,API etc industries.But still,we need a necessary factor to achieve success-THAT IS YOU! Shanghai PU Exhibition( Booth No. N. Http:www.organometal.com ( Copy the link. Changzhou Chemistar Chemistry Technology Co., Ltd-ProductsPolyurethane, Silicone, Resin, API and so on.